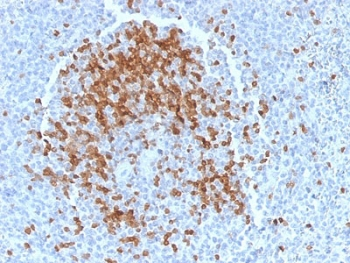
TCL1 Antibody

You have no items in your shopping cart.
Cart summary
Item 1 of 3
Item 1 of 3
TCL1 Antibody
Catalog Number: orb606861
Product Properties
| Catalog Number | orb606861 |
|---|---|
| Category | Antibodies |
| Description | T-cell leukemia/Lymphoma Protein 1A (TCL-1A), also known as p14TCL1 is a product of the TCL1 gene that is involved in T-cell prolymphocytic leukemia (TPLL). T-PLL is a rare form of mature T-cell leukemia, which is consistently associated with chromosomal rearrangements characterized by the juxtaposition of the TCRA locus on chromosome 14q11 and the TCL1A gene on 14q32.13. TCL1 is overexpressed in Burkitt lymphoma, the majority of AIDS-related non-Hodgkin lymphoma-designated immunoblastic plasmacytoid lymphoma, lymphoblastic lymphoma, chronic lymphocytic leukemia, mantle cell lymphoma, follicular lymphoma, diffuse large B-cell lymphoma, and primary cutaneous B-cell lymphoma. |
| Clonality | Recombinant |
| Species/Host | Rabbit |
| Isotype | Rabbit IgG, kappa |
| Conjugation | Unconjugated |
| Reactivity | Human |
| Immunogen | A portion of amino acids 2-109 from the human protein was used as the immunogen for the recombinant TCL1 antibody. |
| UniProt ID | P56279 |
| Tested applications | IHC-P |
| Dilution range | Immunohistochemistry (FFPE): 1-2ug/ml for 30 min at RT |
| Application notes | Optimal dilution of the recombinant TCL1 antibody should be determined by the researcher.1. The prediluted format is supplied in a dropper bottle and is optimized for use in IHC. After epitope retrieval step (if required), drip mAb solution onto the tissue section and incubate at RT for 30 min. |
| Antibody Type | Primary Antibody |
| Clone Number | TCL1/2747R |
| Formula | 0.2 mg/ml in 1X PBS with 0.1 mg/ml BSA (US sourced) and 0.05% sodium azide |
| Storage | Maintain refrigerated at 2-8°C for up to 2 weeks. For long term storage store at -20°C in small aliquots to prevent freeze-thaw cycles. |
| Research Area | Cancer |
| Note | For research use only |
Images

IHC testing of FFPE human tonsil with recombinant TCL1 antibody. HIER: boil tissue sections in pH9 10 mM Tris with 1 mM EDTA for 10-20 min followed by cooling at RT for 20 min.

IHC testing of FFPE human tonsil with recombinant TCL1 antibody. HIER: boil tissue sections in pH9 10 mM Tris with 1 mM EDTA for 10-20 min followed by cooling at RT for 20 min.

SDS-PAGE analysis of purified, BSA-free TCL1 antibody as confirmation of integrity and purity.
Similar Products
Reviews
TCL1 Antibody (orb606861)
Based on 0 reviews
Participating in our Biorbyt product reviews program enables you to support fellow scientists by sharing your firsthand experience with our products.
Login to Submit a Review